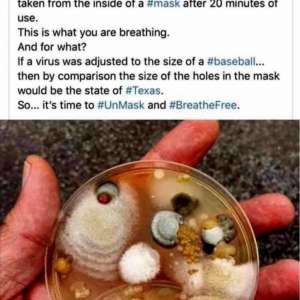
Image

12 March, 05:57
I won't speak to anyone wearing a mask. Show me the respect of displaying your face and speaking clearly, or shut up.
Notice: Undefined index: tg1tga_access in /home/admin/www/anonup.com/themes/default/apps/timeline/post.phtml on line 396
I am wearing a mask because I had double Covid Pneumonia, so I avoid getting the flu or kind of cold. It set up lungs back in healing. No I didn't get vaxed
09:19 PM - Mar 13, 2022
In response Martin Geddes to his Publication
Only people mentioned by Eaglesfly in this post can reply
Celery Juicer
@Emme
14 March, 05:26
In response Qmeeting LDKnepper to his Publication
The mask caused the pneumonia. My husband is mostly dead from wearing his mask! it was the masks that killed people during the 1918 flu epidemic.
Notice: Undefined index: tg1tga_access in /home/admin/www/anonup.com/themes/default/apps/timeline/post.phtml on line 396
Mr. Bee+G&J
@JohnQpublic
13 March, 09:53
In response Qmeeting LDKnepper to his Publication
last image is most telling
Notice: Undefined index: tg1tga_access in /home/admin/www/anonup.com/themes/default/apps/timeline/post.phtml on line 396
Mr. Bee+G&J
@JohnQpublic
13 March, 09:50
In response Qmeeting LDKnepper to his Publication
you got pneumonia because of wearing the mask
and that a fact
if you ran a hose from the exhaust pipe of your car back to the intake how long do you think it will work without fresh air
5 pics all worthy
i hope you can find a way to rise above the mask and return to fresh air without fear
fyi 40,000 units of vitamin c per hour can cure pneumonia
and that a fact
if you ran a hose from the exhaust pipe of your car back to the intake how long do you think it will work without fresh air
5 pics all worthy
i hope you can find a way to rise above the mask and return to fresh air without fear
fyi 40,000 units of vitamin c per hour can cure pneumonia
Notice: Undefined index: tg1tga_access in /home/admin/www/anonup.com/themes/default/apps/timeline/post.phtml on line 396